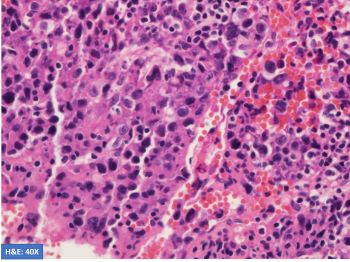
Morlote_Case_4_2023.jpg

Case History
A 52-year-old man with HIV presents with weight loss and supraclavicular mass. Biopsy shows large, atypical cells with the following phenotype: CD45+, CD20-, PAX5 weak, CD3-, CD15-, CD138-, EBER-ISH+. H&E and stains for CD30 and CD79a are shown.

What is the diagnosis?
A. Anaplastic large cell lymphoma associated with immune deficiency.
B. Classic Hodgkin lymphoma associated with immune deficiency.
C. Grey zone lymphoma with primary extra-mediastinal presentation.
D. EBV-positive diffuse large B-cell lymphoma associated with immune deficiency.
Answer: D. EBV-positive diffuse large B-cell lymphoma associated with immune deficiency.
Discussion:
This is a case of EBV-positive diffuse large B-cell lymphoma associated with immune deficiency with an unusual phenotype. B-cell markers are downregulated with negative CD20 and weak expression of PAX5 and CD79a. The unusual phenotype combined with CD30 positivity raises the possibility of Classic Hodgkin lymphoma (CHL). However, the neoplastic cells are positive for CD45 and negative for CD15, making CHL unlikely. Plasmablastic lymphoma was excluded by CD138 negativity.
Source: Ott, G. (Ed.). Anagnostopoulos, I. (Author). (2022). EBV-positive diffuse large B-cell lymphoma. In WHO Classification of tumors online: Haematolymphoid tumours (5th edition). https://tumourclassification.iarc.who.int/chaptercontent/63/149
Case contributed by: Diana Morlote, M.D., Assistant Professor, Genomic Diagnostics and Bioinformatics, Director, Outreach Service Labs, McDonald Clinic and Urgent Care, UAB Pathology